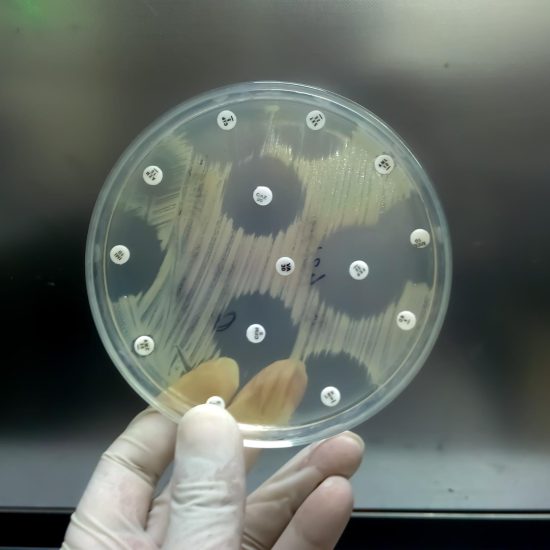
Ceramide

Why Aging Muscles Struggle to Recover
Muscle loss is one of the most common consequences of growing older. Many people assume it is simply inevitable. However, new research from Duke-NUS Medical School, in collaboration with Singapore General Hospital and Cardiff University, reveals a specific molecular culprit behind this decline — a protein called DEAF1.
The findings, published in the Proceedings of the National Academy of Sciences (PNAS), offer a clearer picture of why aging muscles weaken. Furthermore, they point toward potential therapies that could help people maintain strength well into old age.
Weak muscles do more than limit mobility. They increase the risk of falls, slow recovery from illness or surgery, and disrupt blood sugar regulation. Because muscle tissue plays a major role in glucose metabolism, protecting muscle health is essential not just for physical strength, but for long-term metabolic stability.
The mTORC1 Pathway and Protein Turnover
Understanding the Body’s Internal Muscle Manager
At the center of this research is a biological pathway called mTORC1. This pathway controls protein production and tissue maintenance within muscle cells. Under normal conditions, mTORC1 balances two essential functions: building new proteins and clearing out damaged ones.
This balance is critical. Healthy muscles need a constant cycle of renewal. When the system works correctly, cells remove old or dysfunctional proteins and replace them with fresh, functional ones. As a result, muscles stay strong and resilient.
However, aging disrupts this system. In older muscles, mTORC1 becomes overactive. It prioritizes building new proteins while neglecting the removal of damaged ones. Over time, these damaged proteins accumulate. They place stress on muscle cells and accelerate weakness and deterioration.
How DEAF1 Disrupts Muscle Health
The Gene Behind the Imbalance
The research team identified the gene DEAF1 as a key driver of this disruption. As people age, DEAF1 levels rise within muscle tissue. Elevated DEAF1 pushes mTORC1 into overdrive, locking muscles into a state of overproduction while blocking essential cleanup processes.
The consequences are significant. Damaged proteins build up inside muscle cells. The muscle loses its ability to repair itself efficiently. Strength declines. Recovery from injury or illness slows.
To confirm these findings, the team conducted experiments in fruit flies and older mice. In both cases, higher DEAF1 levels caused rapid muscle weakness. Conversely, reducing DEAF1 restored protein balance and improved muscle strength. These results demonstrate that DEAF1’s role is conserved across different species — a strong indicator of its biological importance.
The Role of FOXO Proteins in Muscle Control
When the Regulatory System Breaks Down
Under normal conditions, proteins called FOXOs keep DEAF1 levels in check. FOXOs act as regulators, preventing DEAF1 from rising too high. Therefore, when FOXOs function properly, the mTORC1 pathway stays balanced.
Unfortunately, FOXO activity decreases with age. As FOXOs weaken, DEAF1 rises unchecked. This shift creates a destructive cycle: less FOXO activity leads to more DEAF1, which leads to greater mTORC1 overactivity, which leads to faster muscle deterioration.
Understanding this regulatory chain helps explain why muscle decline accelerates in older adults — and why simply eating more protein or training harder may not be enough to reverse it.
How Exercise Fights Back Against DEAF1
Physical Activity as a Molecular Reset
One of the most encouraging findings of this study is that exercise can restore molecular balance in aging muscles. Physical activity activates certain proteins that lower DEAF1 levels. When DEAF1 drops, mTORC1 returns to a healthier, balanced state. Muscles then regain their ability to clear damaged proteins, rebuild tissue, and maintain resilience.
Assistant Professor Tang Hong-Wen, the study’s lead author, explained that exercise effectively corrects the imbalance caused by aging. It acts as a molecular reset, reactivating the processes that keep muscles functional and strong.
Priscillia Choy Sze Mun, the study’s first author and a research assistant at Duke-NUS, described it simply: exercise tells muscles to “clean up and reset.” Lowering DEAF1 helps older muscles regain that capacity.
This finding reinforces what researchers have long suspected — that exercise is one of the most powerful tools available for healthy aging.
What Happens When Exercise Is Not Enough
The Limits of Physical Activity in Advanced Aging
Despite exercise’s benefits, the study also reveals an important limitation. When DEAF1 levels remain too high — or when FOXO activity drops too far — exercise alone may not fully restore the muscle repair process. This situation is more likely in very advanced age or in muscles that have already experienced significant deterioration.
In these cases, targeting DEAF1 directly may offer a more effective solution. Scientists believe that therapies designed to reduce DEAF1 activity could replicate some of the molecular effects of exercise. Consequently, such treatments could support muscle health even in individuals who are unable to exercise due to illness, surgery, or chronic conditions.
Implications for Medicine and Aging Care
Beyond the Gym: Clinical and Therapeutic Potential
The implications of this research extend well beyond sports science or fitness. DEAF1 also affects muscle stem cells — specialized cells responsible for tissue repair and regeneration. These stem cells naturally decline with age. When DEAF1 is unbalanced, their regenerative capacity weakens even further, slowing recovery across the board.
Accordingly, targeting DEAF1 could benefit a wide range of patients. People recovering from cancer treatment, major surgery, or prolonged illness often experience severe muscle loss. A therapy that restores DEAF1 balance could accelerate their recovery and improve outcomes.
Moreover, this research contributes to a broader scientific effort to understand sarcopenia — the clinical term for age-related muscle loss — and develop targeted interventions. Rather than accepting muscle decline as inevitable, scientists now have a specific molecular target to pursue.
Key Takeaways
- DEAF1 is a gene-encoded protein that rises in aging muscles and disrupts normal protein turnover.
- It overactivates the mTORC1 pathway, causing damaged proteins to accumulate and muscles to weaken.
- FOXO proteins normally regulate DEAF1, but their activity declines with age.
- Exercise lowers DEAF1 levels and can restore muscle balance — but only when the regulatory system still functions adequately.
- Targeting DEAF1 directly could offer new therapies for older adults and patients with limited mobility.
- Research was conducted in fruit flies and mice, confirming DEAF1’s role across species.